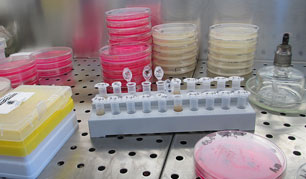
物料測(cè)試與分析

電腦配色與測(cè)色
收到客戶顏料色母粒需求,提供標(biāo)準(zhǔn)樣品可以是成形品,標(biāo)準(zhǔn)色母粒,Pantone。說(shuō)明著色樹(shù)脂類型,生產(chǎn)工藝,戶外用品還是室內(nèi)用品等要求,注明特殊要求。進(jìn)行配色,一般樣品(色母粒2-3、色粉1-2)個(gè)工作日內(nèi)寄出到達(dá)客戶,加急另行協(xié)商??蛻舸_認(rèn)顏色及性能后,我們安排上機(jī)批量生產(chǎn),針對(duì)塑料配色,通過(guò)現(xiàn)有的基礎(chǔ)色彩,可配出幾乎所有的顏色
物料測(cè)試與分析

提供產(chǎn)品著色設(shè)計(jì)和選材方案



承接各種材料染色造粒(提供抽粒加工、塑料改性服務(wù))




生產(chǎn)銷售塑料特殊用途功能母粒
包括:抗靜電母粒、光擴(kuò)散母粒、抗氧化母粒、激光防偽母粒、防霧滴母粒、開(kāi)口/爽滑母粒、抗UV母粒、PP增透母粒、阻燃母粒、PPA母粒等